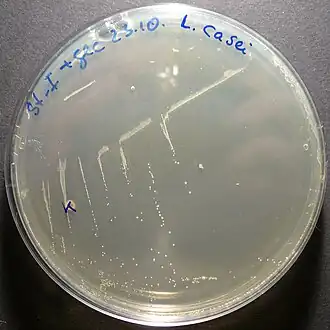
Description de cette image, également commentée ci-après

Lactobacillus casei
| Domaine | Bacteria |
|---|---|
| Division | Firmicutes |
| Classe | Bacilli |
| Ordre | Lactobacillales |
| Famille | Lactobacillaceae |
| Genre | Lactobacillus |
Lactobacillus casei est une espèce de bactérie lactique de la famille des Lactobacillaceae. Cette bactérie a été isolée dans le lait, le fromage et le tractus gastro-intestinal de l'homme, du cochon et des oiseaux[1].
Certaines souches de L. casei sont utilisées comme probiotique dans l'industrie des laits fermentés et comme ferments lactiques participant au développement des arômes dans l’affinage des fromages (emmental, comté, saint-nectaire, parmesan, cheddar).
Description
L. casei est en forme de bâtonnet, de 0,7-1,1 x 2,0-4,0 µm, avec les extrémités carrées. C'est une bactérie non mobile et hétérofermentaire facultative (les sucres peuvent être fermentés via la voie de la glycolyse ou la voie des pentoses phosphates) Elle demande les facteurs de croissance suivants : la riboflavine, l'acide folique, le pantothénate de calcium et la niacine sont essentiels; le pyridoxal et la pyridoxamine (formes de la vitamine vitamine B6) sont essentiels ou stimulants alors que la thiamine, la vitamine B12 ou la thymidine ne sont pas requis. Sa croissance est optimale à 15 °C mais pas à 45 °C. Comme les lactobacilles, elle est Gram-positive, non sporulée.
Étymologie et histoire de la taxonomie
Étymologie : du latin scientifique casei « du fromage » (génitif de caseus « fromage »)
Sous-espèces[2] :
- Lactobacillus casei subsp. alactosus Mills and Lessel 1973
- Lactobacillus casei subsp. casei (Orla-Jensen 1916) Abo-Elnaga and Kandler 1965
- Lactobacillus casei subsp. pseudoplantarum Abo-Elnaga and Kandler 1965
- Lactobacillus casei subsp. rhamnosus Hansen 1968
- Lactobacillus casei subsp. tolerans Abo-Elnaga and Kandler 1965
Les études phylogénétiques récentes ont conduit à répartir les souches de L. casei entre plusieurs espèces : L. paracasei, L. zeae et L. casei (Collins et al 1989, Chen et al. 2000).
Lactobacillus casei fut d'abord décrit par Sigurd Orla-Jensen en 1919 (Ljungh et als[3], 2009). Hansen et Lessel choisirent en 1971 la souche ATCC 393 comme souche néotype sur la base de quelques traits phénotypiques. Les expériences d'hybridation ADN-ADN de Dellaglio et als 1975 montrèrent que la souche ATCC 393T avait de grandes similarités avec la souche Lactobacterium zeae et ne constituait donc pas le meilleur néotype de L. casei. Collins et als 1989, sur la base d'expériences d'hybridation ADN-ADN, confirmèrent la position à part de la souche ATCC 393T et transfèrent toutes les autres souches de L. casei dans une nouvelle espèce L. paracasei. En 1996, Dick et als reclassèrent L. casei subsp. casei ATCC 393T et Lactobacterium zeae ATCC 15820 comme L. zeae nom. rev.et désignèrent la souche ATCC 334 comme néotype de L. casei subsp. casei .
Par conséquent, la bactérie L. casei que l'on trouve dans de nombreuses applications alimentaires, est aujourd'hui réduite à quelques souches, tels qu'ATCC 393T et NCFB 173. Presque toutes les autres souches de L. casei, beaucoup d'entre elles utilisées dans les fermentations alimentaires ou dans des formulations probiotiques, doivent être nommées L. paracasei subsp. paracasei[N 1].
Ces changements de noms récurrents viennent du fait que la taxonomie dépend de nouvelles méthodes d'études et de nouveaux taxons, mais il faut prendre garde à ce qu'ils n'impactent pas trop la nomenclature qui doit elle rester relativement stable.
Utilisations
Lactobacillus casei a été l'objet de très nombreuses études ces dernières décennies en raison de l'importance économique de ses utilisations dans l'alimentation humaine soit comme probiotique dans les laits fermentés soit comme levain dans les fermentations alimentaires (fromages, olives).
- Probiotique
Dès les années 1950, la souche Lactobacillus casei Shirota fut considérée par les fabricants de produits laitiers Japonais Yakult comme un probiotique. Puis vint Danone qui lança en 1997 Actimel avec la souche Lb. casei DN-114 001. Les effets revendiqués par Yakult étaient une régulation du transit et un renforcement des défenses naturelles alors que pour Danone, Actimel pouvait renforcer les défenses naturelles de l'organisme[4]. Actuellement, le nombre de nouveaux produits laitiers contenant des probiotiques ne cessent d'augmenter. En 2005, Actimel représentait déjà un milliard d'euros de chiffre d'affaires[5].
La communauté scientifique est restée longtemps assez sceptique quant aux effets bénéfiques sur la santé de L. casei. Il faut reconnaître que le manque de fondement scientifique, l'ignorance des mécanismes mis en jeu dans les effets observés, ainsi que les allégations santé non confirmées ont entretenu le doute. Néanmoins, devant les enjeux économiques considérables, se sont multipliées ces dernières années des études cliniques enfin sérieuses, menées chez l'homme et l'animal, qui ont montré les effets bénéfiques précis de certaines bactéries lactiques, sur des symptômes cliniques donnés (Rochet et Langella[5], 2009).
Plusieurs études ont montré l'efficacité de préparations probiotiques très fortement concentrées. C'est dans le traitement de la pochite, une complication fréquente suivant une anastomose iléo-anale, que les probiotiques ont donné leurs meilleurs résultats en pathologie.
Une équipe italienne (Campieri M, Gionchetti P[6]) a traité en double aveugle 40 patients mis en rémission de leur pochite chronique par un traitement antibiotique. Après un traitement de 9 mois, par un mélange de bactéries lactiques VSL#3 versus placebo, 85 % des patients du groupe VSL#3 étaient toujours en rémission contre 0 % sous placebo. Une autre étude de Gionchetti[7] a récemment présenté les résultats des effets de l'administration quotidienne pendant 4 semaines d'un probiotique composé d'un mélange de bactéries lactiques VSL#3 (à raison de 3600 milliards de bactéries par jour) chez 23 patients atteints de pochite chronique. Après traitement 69 % des patients étaient en rémission. Cette préparation VSL#3 est composée de trois espèces de bifidobactéries (Bifidobacterium breve, B. longum, B. infantis) et de 4 espèces de lactobacilles : Lactobacillus casei (ou paracasei), Lb. acidophilus, Lb. plantarum, Lb. bulgaricus et Streptococcus thermophilus.

Le lait fermenté probiotique Actimel, à base de Lactobacillus, a montré son efficacité dans la prévention des diarrhées liées aux antibiotiques. Un essai randomisé, en double aveugle, versus placebo[8] portant sur 135 patients hospitalisés prenant des antibiotiques a consisté à leur faire prendre une boisson contenant Lactobacillus casei, Lb. bulgaricus et Streptococcus thermophilus (de l'Actimel deux fois par jour) durant leur traitement et une semaine après, versus un groupe placebo qui prenait un milk-shake. Dans le groupe probiotique, 12 % des patients ont développé une diarrhée comparé à 34 % dans le groupe placebo. Personne du groupe probiotique n'a développé de diarrhée à Clostridium difficile alors que 17 % du groupe placebo en a eu.
Deux études randomisées et contrôlées de Aso et ses collaborateurs[9],[10] (1992, 1995), ont montré que l'administration orale de Lactobacillus casei souche biolactis pouvaient diminuer de manière significative le risque de récidive de tumeurs superficielles de la vessie chez l'homme.
De nombreuses études ont porté aussi sur les probiotiques pour lutter contre la bactérie Helicobacter pylori associée à l'ulcère et au cancer de l’estomac. Une méta-analyse[11] d'essais randomisés (de 963 patients dont un groupe contrôle de 465) conclut que les préparations probiotiques à base de lait fermenté peuvent améliorer le taux d'éradication d'H. pylori d'environ 5-15 %.
De nombreux autres effets sont actuellement étudiés mais ils restent à confirmer. Ainsi un effet préventif vis-à-vis du cancer colorectal et les effets sur le système immunitaire demandent confirmation.
- Fermentations alimentaires
L. casei est également l'espèce dominante dans la fermentation naturelle des olives vertes siciliennes[12]. Les méthodes conventionnelles d'analyse de la fermentation des olives vertes avaient permis de détecter une population microbienne très variable comportant Lactobacillus plantarum, Lb. casei, Lb. brevis et Enterococcus faecum mais la technique de séquençage partiel de l'ADNr 16S a mis en évidence que plus de 50 % des souches appartenaient à l'espèce L. casei
Dans tous les fromages Lactobacillus casei et Lb. plantarum sont présents en nombre appréciable en raison de leur développement au cours de l'affinage[13]. Dans les pâtes pressées cuites, ils atteignent 107 à 108 en fin de maturation et participent à la formation des arômes.
Il a été démontré que l'addition de lactobacilles hétérofermentaires facultatifs sous forme de Lactobacillus casei inhibait la fermentation proprionique dans la formation d'emmental[14]. L'écosystème microbien de ce fromage est constitué de trois flores principales : les bactéries lactiques thermophiles (Lb. delbruckii, Lb. helveticus), les bactéries propioniques et les lactobacilles hétérofermentaires facultatif (L. casei). Le défaut de fermentation tardive peut être évité en ajoutant L. casei (et en omettant Lactobacillus helveticus une bactérie homofermentaires obligatoire, thermophile, ainsi qu'en utilisant un levain propionique à faible activité aspartate).
Lactobacillus casei a été aussi détecté dans des fromages à pâtes dures comme le parmigiano reggiano (parmesan), dans les fromages à pâte semi dure comme le saint-nectaire[15].
Ces dernières années, de nombreuses études sur la décoloration des teintures azoïques par les bactéries lactiques telles que L. casei TISTR 1500, L. paracasei, Oenococcus oeni ont été menées. Avec l'activité azoréductase, les mono- et di-liaisons azoïques sont complètement dégradées, et génèrent d'autres composés aromatiques intermédiaires.
Enfin, signalons le rôle de Lb. casei et de Lb. plantarum dans la fermentation des matières dans le tube digestif, à l'origine de la production des gaz intestinaux, responsables des flatulences.
Lactobacillus casei DN-114001
Le lait fermenté Actimel contient, en plus des deux souches spécifiques des yaourts (Lactobacillus delbrueckii subsp. bulgaricus et Streptococcus thermophilus), un probiotique, issu de la recherche de Danone, le Lactobacillus casei DN-114 001 (appelé aussi Lactobacillus casei defensis, ou L. casei Danone). Chaque dose de 100 mL contient près de 10 milliards de ces bactéries probiotiques, en plus des bactéries naturellement présentes, et ce pendant toute la durée de conservation, dans les conditions normales de stockage à 4 °C. Le processus de fabrication est analogue à celui des yaourts à boire. Il consiste en un mélange de lait fermenté avec Lb. casei DN-114001 et d'un lait fermenté sucré, avec les deux souches traditionnelles du yaourt, préparé suivant la méthode standard des yaourts brassés[16]. La fermentation se ferait sur trois jours contrairement à celle d'un yaourt qui dure 4 heures[17].
Plusieurs études ont montré que L. casei Defensis survit dans l'environnement acide de l'estomac et de l'intestin grêle et arrive vivant dans le côlon où il modifie provisoirement la microflore intestinale[16],[18].
Lancé en 1997, Actimel a d'abord connu un succès fulgurant en Espagne, Allemagne, France et Angleterre. Puis les ventes ont stagné de 2005 à 2010, avant de connaître un recul[19]. Le produit serait victime de critiques, tantôt jugé trop sucré ou trompeur sur ses bienfaits.
Récemment, le principal argument de vente était que ce produit « consommé chaque jour, renforce les défenses naturelles grâce à ses cultures spéciales L. Casei Danone »[20]. Mais avant 2004, les allégations de santé étaient plus étendues et concernaient trois autres points « aide à la régulation du système immunitaire, aide le corps à bien se défendre, aide votre intestin à repousser certaines bactéries indésirables ». À la suite d'une demande d'évaluation des justificatifs scientifiques concernant les allégations de santé, l'AFSSA (Agence française de sécurité sanitaire des aliments) indique[21] qu'elles sont non recevables car « malgré les données expérimentales convaincantes relatives aux propriétés de Lactobacillus casei DN-114 001 sur la modulation et la régulation de certains paramètres de la réponse immunitaire, les résultats cliniques sont parcellaires et insuffisants pour démontrer l'effet du produit sur le système immunitaire ». Que l'allégation « aide le corps à bien se défendre » est trop imprécise et globale ce qui la rend invérifiable et que l'aide à repousser certaines bactéries repose sur « un rationnel scientifique parcellaire et insuffisant ».
Quatre ans plus tard, aux États-Unis, ces considérations se traduiront par des déboires judiciaires pour Danone. Les allégations de santé d'Actimel feront l'objet d'un recours collectif en [22],[23]. Les consommateurs américains impliqués dans cette action visaient à prouver que « les vertus santé avancées […] n'étaient pas prouvées ». Danone a décidé de régler à l'amiable ce litige en proposant 35 millions de dollars de dédommagement aux plaignants et a également décidé de modifier l'emballage de son produit pour y faire disparaître le mot « immunité »[24].
Après le revers américain, c'est au Royaume-Uni d'interdire les publicités pour le produit, estimant que les estimations de santé n'étaient pas suffisamment étayées[25]. Cette décision de l'Advertising Standards Authority (ASA), en , touche Danone qui avait pourtant présenté 23 études menées sur plus de 6 000 personnes de tous âges à l'appui de ses spots télévisés.
Le , selon une dépêche de l’AFP, « Danone a annoncé jeudi le retrait en Europe de toutes allusions aux bénéfices pour la santé de ses laitages Activia et Actimel dans ses campagnes publicitaires déjà modifiées en France, aux États-Unis, et en Grande-Bretagne, où elles ont été jugées trompeuses. […] Parallèlement, Danone a indiqué qu’il retirait sa demande de validation auprès de l’autorité européenne de sécurité des aliments (EFSA) des produits Activia et Actimel, ces deux laitages devant faire l’objet d’un avis du gendarme européen dans les « semaines à venir »[25]. Des années de recherches scientifiques effectuées par Danone n'ont pas été suffisantes pour convaincre l'EFSA des bienfaits du produit sur la santé.
Lactobacillus casei Shirota
Liens externes
Notes
- ↑ toute cette section est redevable de Ljungh et als 2009
Références
- ↑ (en) Paul Vos, Bergey's Manual of Systematic Bacteriology : Volume 3 : The Firmicutes, Springer, , 1450 p. (ISBN 978-0-387-68489-5, lire en ligne)
- ↑ LPSN
- ↑ (en) Åsa Ljungh, Lactobacillus molecular biology : from genomics to probiotics, Norfolk, UK, Caister Academic, , 205 p. (ISBN 978-1-904455-41-7 et 1904455417)
- ↑ Esther Izquierdo Alegre, Les protéines bactériennes en tant que biomarqueurs de l'activité probiotique, Thèse de chimie analytique, Université de Strasbourg, IPHC,
- 1 2 Djamel Drider et Hervé Prévost, Bactéries lactiques, Physiologie, Métabolisme, Génomique et Applications industrielles, Economica, , 594 p., chap. VI (« Bactéries lactiques et santé, Les probiotiques, de T. Rochat et P. Langella »)
- ↑ Campieri M, Gionchetti P, « Probiotics in inflammatory bowel disease : new insight to pathogenesis or a possible therapeutic alternative ? », Gastroenterology, vol. 116, , p. 1246-9
- ↑ Paolo Gionchetti, « High-Dose Probiotics for the Treatment of Active Pouchitis: », Diseases of the Colon & Rectum, vol. 50, no 12, , p. 2075-2084 (ISSN 0012-3706, DOI 10.1007/s10350-007-9068-4, lire en ligne, consulté le )
- ↑ Mary Hickson, « Use of probiotic Lactobacillus preparation to prevent diarrhoea associated with antibiotics: randomised double blind placebo controlled trial », BMJ, vol. 335, no 7610, , p. 80 (ISSN 0959-8138 et 1468-5833, DOI 10.1136/bmj.39231.599815.55, lire en ligne, consulté le )
- ↑ Y Aso, « Preventive effect of a Lactobacillus casei preparation on the recurrence of superficial bladder cancer in a double-blind trial. The BLP Study Group », European urology, vol. 27, no 2, , p. 104-109 (ISSN 0302-2838)
- ↑ Y Aso, « Prophylactic effect of a Lactobacillus casei preparation on the recurrence of superficial bladder cancer. BLP Study Group », Urologia internationalis, vol. 49, no 3, , p. 125-129 (ISSN 0042-1138)
- ↑ Aarti Sachdeva, « Effect of fermented milk-based probiotic preparations on Helicobacter pylori eradication: a systematic review and meta-analysis of randomized-controlled trials: », European Journal of Gastroenterology & Hepatology, vol. 21, no 1, , p. 45-53 (ISSN 0954-691X, DOI 10.1097/MEG.0b013e32830d0eff, lire en ligne, consulté le )
- ↑ Cinzia L. Randazzo, Cristina Restuccia, A. Daniele Romano, Cinzia Caggia, « Lactobacillus casei, dominant species in naturally fermented Sicilian green olives », International Journal of Food Microbiology, vol. 90, , p. 9-14 (lire en ligne)
- ↑ André Eck et Jean-Claude Gillis, LE FROMAGE, de la science à l'assurance-qualité, TEC&DOC, lavoisier, 2006 (tir. 2009), chap. 10 (« Les phénomènes microbiens par C. Choisy et als »)
- ↑ Marie-Therese Fröhlich-Wyder, « Interaction between propionibacteria and starter / non-starter lactic acid bacteria in Swiss-type cheeses », Le Lait, vol. 82, no 1, , p. 1-15 (ISSN 0023-7302 et 1297-9694, DOI 10.1051/lait:2001001, lire en ligne, consulté le )
- ↑ Emilie Retureau, Reconstitution de communautés microbiennes complexespour l’inhibition de Listeria monocytogenes à la surface defromages à pâte pressée non cuite, Thèse, Université Blaise Pascal,,
- 1 2 Géraldine Favre, Prébiotiques et probiotiques : ont-ils un réel intérêt pour la santé? Rôle du pharmacien dans leur conseil à l'officine, Thèse, doctorat en pharmacie, Université Joseph Fourier,
- ↑ blog
- ↑ EFSA Panel on Dietetic Products, Nutrition and Allergies (NDA), « Scientific Opinion on the substantiation of a health claim related to fermented milk containing Lactobacillus casei DN-114 001 plus yoghurt symbiosis (Actimel®), and reduction of Clostridium difficile toxins in the gut of patients receiving antibiotics and reduced risk of acute diarrhoea in patients receiving antibiotics pursuant to Article 14 of Regulation (EC) No 1924/20061 », EFSA Journal, vol. 8, no 12, (lire en ligne)
- ↑ Figaro
- ↑ Actimel
- ↑ avis du 23 janvier 2004 afssa
- ↑ (en) « Dannon sued over probiotic yogurt claims », CTV News, 24 janvier 2008.
- ↑ (en) « Dannon Refutes Class Action Lawsuit Alleging Misleading Claims »(Archive.org • Wikiwix • Archive.is • Google • Que faire ?), Reuters, 24 janvier 2008.
- ↑ « Le double langage de Danone », Que Choisir, no 475, novembre 2009, p. 7.
- 1 2 droit medical
- Portail de la microbiologie